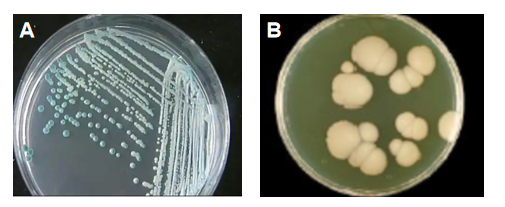

1.白色念珠菌(Candida albicans)
物种名:白色念珠菌
拉丁学名:Candida albicans
分类学地位:真菌界Fungi;子囊菌门Ascomycota;
酵母菌纲Saccharomycetes;酵母菌目Saccharomycetales;
酵母菌科Saccharomycetaceae;念珠菌属Candida;
白色念珠菌是一种二相性真菌,既是人体口腔、肠道和阴道黏膜的常见共生菌,也是最重要的人类机会性致病真菌。在宿主免疫功能正常时,它通常无害;然而,当宿主免疫力下降或菌群失调时,它可从共生状态转为致病状态,引起从浅表黏膜感染(如鹅口疮、阴道炎)到危及生命的侵袭性全身感染(如念珠菌血症)等多种疾病。
1.1生物学特性
1.1.1培养特征
白色念珠菌在大多数真菌培养基上生长快速,最适生长温度为37℃。在沙氏葡萄糖琼脂(SDA)培养24-48小时后,形成中等大小、圆形、乳白色、表面光滑湿润、质地柔软的酵母样菌落,并带有特殊的酵母气味。显色培养基(CHROMagar™ Candida)是临床上快速鉴别念珠菌的常用培养基。白色念珠菌因其特有的酶(如己糖胺酶),在该培养基上会形成特征性的绿色菌落,可与其他念珠菌(如克柔氏念珠菌的粉色、热带念珠菌的蓝色)区分开[1]。
图1 白色念珠菌培养结果
A:沙氏葡萄糖琼脂下的白色念珠菌,B:沙鲍弱氏琼脂下的白色念珠菌
1.1.2形态学特征
c
白色念珠菌具有典型的二相性,即可在酵母相和菌丝相之间转换:酵母相(图2D和图2E)是指在常规培养条件下,呈卵圆形,大小为3-5 µm,通过出芽方式繁殖。革兰氏染色呈阳性,但菌体比细菌大得多。菌丝相(图2F)是在特定条件下(如在血清中37℃孵育),酵母细胞会长出芽管(Germ tube),这是快速鉴定白色念珠菌的经典特征。它还能形成假菌丝和真菌丝[2]。
除了作为双态性真菌,白色念珠菌可以在酵母菌型态与菌丝型态间转换之外,还可以进行通称为“高频率转换”(high-frequency switching)之多种其他表型间的转换,其中被研究最多的一种转换则是某些菌株白色型-混浊型间的转换(图2B和图2C)[8],另外还有许多其他不同的转换系统,例如SC5314菌株可在七种表型间互相转换[9, 10]。酵母菌型-菌丝型转换的过程相当快速,且通常整个菌落的所有细胞都会一起转换;高频率转换则可能只在菌落中的部分细胞中发生,且经转换后的细胞通常仍能进行酵母菌型-菌丝型转换。这些转换均为可逆,且常受到二氧化碳浓度、氧气浓度、培养基种类与温度等环境因子的影响[11]。

图2 白色念珠菌的各种形态
A:扫描电子显微镜下的白色念珠菌,B:平滑型白色念珠菌,C:皱纹型白色念珠菌,
D:酵母菌型白色念珠菌(正进行出芽生殖),E:酵母菌型白色念珠菌(形成假菌丝),
F:菌丝型白色念珠菌
1.1.3生化特征
白色念珠菌具有一系列独特的生化特性,是其实验室鉴定的关键依据。其中最快速且特异的表型是芽管形成试验阳性,即在37°C的血清或血浆中孵育2-3小时,其酵母细胞可长出无隔的短丝状结构(芽管)。在玉米粉吐温-80等贫营养培养基上,它能形成顶生的、壁厚圆形的厚膜孢子,这是区别于其他常见念珠菌的重要形态特征。在糖代谢方面,它能发酵葡萄糖和麦芽糖产酸产气,通常也能发酵蔗糖,但不能发酵乳糖。在现代诊断中,其在显色培养基上可凭借特异性酶(如己糖胺酶)水解色原底物而形成特征性的绿色或蓝绿色菌落,从而与其他念珠菌(常呈粉色、紫色或白色)快速区分。此外,其尿素酶试验呈阴性,有助于与隐球菌等其他酵母样真菌鉴别。
1.1.4分子生物学特征
鼻白色念珠菌的致病性由多种毒力因子决定,主要包括:
(1)形态转换:从酵母相到菌丝相的转换是其侵袭宿主组织的关键。菌丝能穿透上皮细胞和内皮细胞,并逃避巨噬细胞的吞噬。
(2)黏附:菌体表面的黏附素(如凝集素样序列蛋白ALS家族)能使其牢固地黏附于宿主细胞和医疗植入物(如导管)表面。
(3)水解酶分泌:分泌的天冬氨酸蛋白酶(SAPs)和磷脂酶(PLs)能降解宿主组织蛋白和细胞膜,帮助菌体侵袭和获取营养。
(4)生物被膜形成:在导管、假牙等表面形成结构复杂的生物被膜,使菌体对宿主免疫和抗真菌药物产生极强的抵抗力[3]。
1.2分布、传播与致病性
1.2.1分布与传播
白色念珠菌为伺机性感染的致病真菌,平时可生长于人体的皮肤与粘膜组织中而不造成负面影响,但当其过度生长时可能造成念珠菌症的感染。念珠菌症又可依感染部位分为若干类型,包括感染口部的鹅口疮、感染阴道的念珠菌性外阴阴道炎、感染食管的念珠菌性食管炎等,甚至可能造成全身的侵入性感染,侵犯多个器官,并造成念珠菌血症(Candidemia)。念珠菌症在健康成人中比较少见,小于一个月的新生儿、艾滋病患者、癌症患者、糖尿病患者与服用抗生素与皮质类固醇等免疫缺乏者感染的风险较高。白色念珠菌也常造成医疗照顾相关感染。该菌可在环境中(如医院水槽、潮湿表面)存活,但非其主要生态位。
1.2.2致病性
白色念珠菌可以分泌天冬氨酸蛋白酶(secreted aspartic proteinases, Saps)、磷脂酶与脂酶,可分解宿主细胞的胞外底物与细胞膜表面物质[12],有助其黏着、侵入宿主的组织中[13],甚至可能可以用以破坏免疫细胞[12]。2016年,有研究发现白色念珠菌感染宿主粘膜时,从酵母菌型转为菌丝型后,会分泌一种称为念珠菌素的毒素,念珠菌素长31个氨基酸,是由Kex2p蛋白酶切割Ece1p产生的一种多肽,可造成宿主上皮细胞的损伤,并刺激宿主的免疫反应[14]。
酵母菌型-菌丝型转换对白色念珠菌的致病能力相当重要。吞噬细胞是宿主抗真菌免疫反应中的重要环节,白色念珠菌被巨噬细胞内吞后,并由酵母菌型转换为菌丝型,最终穿透巨噬细胞而重新回到组织中。在巨噬细胞内部,白色念珠菌会启动许多基因的表现,改变其代谢与促进型态转换,其中许多基因为念珠菌所特有,酿酒酵母中不存在同源基因者,很可能与白色念珠菌的致病能力有关[15]。另外菌丝型的白色念珠菌菌丝表面有Hwp1(Hyphal wall protein 1)蛋白,该蛋白可与宿主上皮细胞表面的转麸酰胺酶结合,有助白色念珠菌黏附于宿主细胞,进而造成感染[16]。
白色念珠菌与机体处于共生状态,不引起疾病。当某些因素破坏这种平衡状态,白假丝酵母菌由酵母相转为菌丝相,在局部大量生长繁殖,引起皮肤、黏膜甚至全身性的假丝酵母菌病。当机体的正常防御功能受损导致内源性感染,如创伤、抗生素应用及细胞毒药物使用致菌群失调或黏膜屏障功能改变、皮质激素应用、营养失调、免疫功能缺陷等。白假丝酵母菌为双相菌,正常情况下一般为酵母相,致病时转化为菌丝相。因此在细胞涂片或组织切片中发现假菌丝是假丝酵母菌感染的重要证据。
白色念珠菌可引起多种念珠菌病。浅表感染常见且易于治疗。侵袭性念珠菌病则是一种严重的院内感染,尤其是念珠菌血症(血液感染),主要发生于ICU患者、免疫抑制患者和接受大手术的患者。侵袭性念珠菌病的粗死亡率极高,可达40%-60%[4]。美国CDC和NIH将白色念珠菌列为生物安全二级(BSL-2)病原体。

图3 口腔念珠菌病(鹅口疮)的临床表现
1.3检测方法
(1)显色培养基鉴定与芽管试验:这是临床微生物实验室最常用、性价比最高的鉴定流程。操作原理为先将临床标本(如血液、痰、分泌物)接种于显色培养基(CHROMagar™ Candida)上,37℃培养24-48小时。观察有无特征性的绿色菌落生长。再挑取绿色菌落,接种于0.5 mL血清中,置于37℃水浴孵育2-3小时。取一滴制成湿片,在显微镜下观察酵母细胞是否长出无隔、无缢缩的芽管。芽管试验阳性是白色念珠菌的经典鉴定特征。该流程遵循中国《全国临床检验操作规程和国际通行的临床微生物学操作规范[2]。
(2)ITS基因测序法:该方法是真菌鉴定的“金标准”,用于对非典型菌株或需要精确鉴定的情况。操作原理为提取菌株DNA,利用真菌通用引物扩增核糖体DNA的内转录间隔区(ITS)。ITS区在种间差异大,在种内相对保守,适于物种鉴定。将PCR产物进行Sanger测序,并将序列与GenBank等公共数据库比对(BLAST),以鉴定物种。其常用引物如表1,反应条件示例为94℃ 5分钟;(94℃ 30秒,55℃ 30秒,72℃ 1分钟)×35个循环;72℃ 10分钟。ITS序列作为真菌条形码(barcode)被广泛接受,其方法和引物在大量真菌学研究中被使用和验证[5]。
表1 白色念珠菌ITS基因测序常用引物序列
| 名称 | 序列 |
| ITS1 | 5′-TCCGTAGGTGAACCTGCGG-3′ |
| ITS4 | 5′-TCCTCCGCTTATTGATATGC-3′ |
1.4典型案例
2014年美国印第安纳州一家医院的NICU在数月内发生了侵袭性念珠菌病暴发,共导致11名早产儿感染,其中5名婴儿死亡。CDC介入调查后,通过全基因组测序技术进行流行病学分析,发现所有患儿感染的白色念珠菌菌株均为同一克隆型。溯源调查最终发现,该菌株定植于一名医护人员的指甲下,并通过其在护理过程中的接触传播给多名新生儿。该事件导致医院立即实施了更严格的手卫生规范和指甲护理政策,并对所有相关人员进行筛查和培训,成功控制了疫情[6]。
2002年台湾一家医学中心发生了一起由污染的肠外营养液(TPN)导致的白色念珠菌血症暴发。在短期内,有15名患者(多为ICU患者)相继出现菌血症。调查发现,所有患者均使用了由医院药剂科配制的TPN。通过对TPN液体、配制环境和操作人员进行采样检测,最终在TPN液体和一名药剂师的手部样本中分离出基因型完全相同的白色念珠菌。事件确认是由于药剂师在无菌配制过程中的操作失误导致TPN污染。该事件促使医院全面审查并改进了静脉输液的无菌配制流程和质量控制体系[7]。
1.5防治对策
(1)医院感染控制:这是预防侵袭性念珠菌病的核心。关键措施包括:严格执行手卫生;对中心静脉导管等侵入性器械进行规范化护理(即集束化干预措施,Bundle care);加强环境清洁消毒。
(2)抗真菌药物的合理使用(抗真菌管理):避免不必要的广谱抗生素(会破坏细菌菌群,利于真菌生长)和抗真菌药物的滥用,以减缓耐药性的产生。
(3)高危人群管理:对ICU、器官移植、长期使用导管等高危患者,需密切监测感染迹象,部分情况下可考虑预防性使用抗真菌药物。
参考文献
- 黄湾, 李若瑜. 念珠菌显色培养基的研究进展. 中国真菌学杂志, 2011, 6: 184-187.
- 中华人民共和国卫生部医政司. 全国临床检验操作规程. 第4版. 南京: 东南大学出版社, 2015.
- 李民, 廖万清. 白色念珠菌生物膜的研究进展. 中国真菌学杂志, 2008, 3: 119-123.
- 中华医学会重症医学分会. 中国侵袭性念珠菌病诊断与治疗指南. 中华内科杂志, 2011, 50: 170-176.
- 白逢彦, 姚一建. 真菌的DNA条形码. 菌物学报, 2011, 30: 663-671.
- CDC. Notes from the Field: An Outbreak of Candida albicans Infections in a Neonatal Intensive Care Unit – Indiana, 2014. MMWR Morbidity and Mortality Weekly Report, 2015, 64: 277.
- Hung LS. Outbreak of Candida albicans fungaemia in a neonatal intensive care unit: a survey using molecular methods. Journal of Hospital Infection, 2003, 55: 292-298.
- Neena Jain, Fahmi Hasan, Bettina C. Fries. Phenotypic Switching in Fungi. Curr Fungal Infect Rep. 2008, 2: 3.
- Slutsky B, Staebell M, Anderson J, Risen L, Pfaller M, Soll DR. “White-opaque transition”: a second high-frequency switching system in Candida albicans.. J. Bacteriol. 1987, 1: 189-197.
- Slutsky B, Buffo J, Soll DR. High-frequency switching of colony morphology in Candida albicans. Science, 1985, 230: 666-669.
- Soll, DR. High-frequency switching in Candida albicans. Clin Microbiol Rev, 1992, 5: 183-203.
- Schaller M, Borelli C, Korting HC, Hube B. Hydrolytic enzymes as virulence factors of Candida albicans. Mycoses, 2005, 48: 365-377.
- Monika S, Małgorzata B, Zbigniew O. Contribution of Aspartic Proteases in Candida Virulence. Protease Inhibitors against Candida Infections. Curr Protein Pept Sci, 2017, 18: 1050-1062.
- Duncan Wilson, Julian R, Naglik, Bernhard Hube. The Missing Link between Candida albicans Hyphal Morphogenesis and Host Cell Damage. PLoS Pathog, 2016, 12: e1005867.
- Lorenz MC, Bender JA, Fink GR. Transcriptional Response of Candida albicans upon Internalization by Macrophages. Eukaryotic Cell, 2004, 3: 1076-1087.
[16] Staab JF. Adhesive and Mammalian Transglutaminase Substrate Properties of Candida albicans Hwp1. Science, 1999, 283: 1535-1538.
.png)
